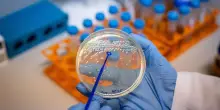

s

Cronaca
Laboratorio Virologia dello Spallanzani è riferimento in consorzio Ue
01-07-2025, 13:12
(Adnkronos) - "Siamo impegnati nel supporto alla diagnosi e alla sorveglianza dei patogeni virali emergenti a trasmissione zoonotica, contribuendo a rafforzare la risposta europea a eventuali focolai epidemici causati da virus ad alta patogenicità tra cui arenavirus, filovirus, hantavirus, henipavirus, lyssavirus, poxvirus e la cosiddetta ‘malattia X’, ovvero un possibile patogeno ad alto potenziale pandemico ancora sconosciuto". Spiega Francesca Colavita, responsabile scientifico del progetto per lo Spallanzani
CONTINUA A LEGGERE

30

0

0
Guarda anche
Adnkronos
03:39
Ue, accordo per l'Ucraina: prestito di 90 miliardi a Kiev
Adnkronos
00:05
Superenalotto, numeri e combinazione vincente 18 dicembre 2025
Adnkronos
Ieri, 23:21